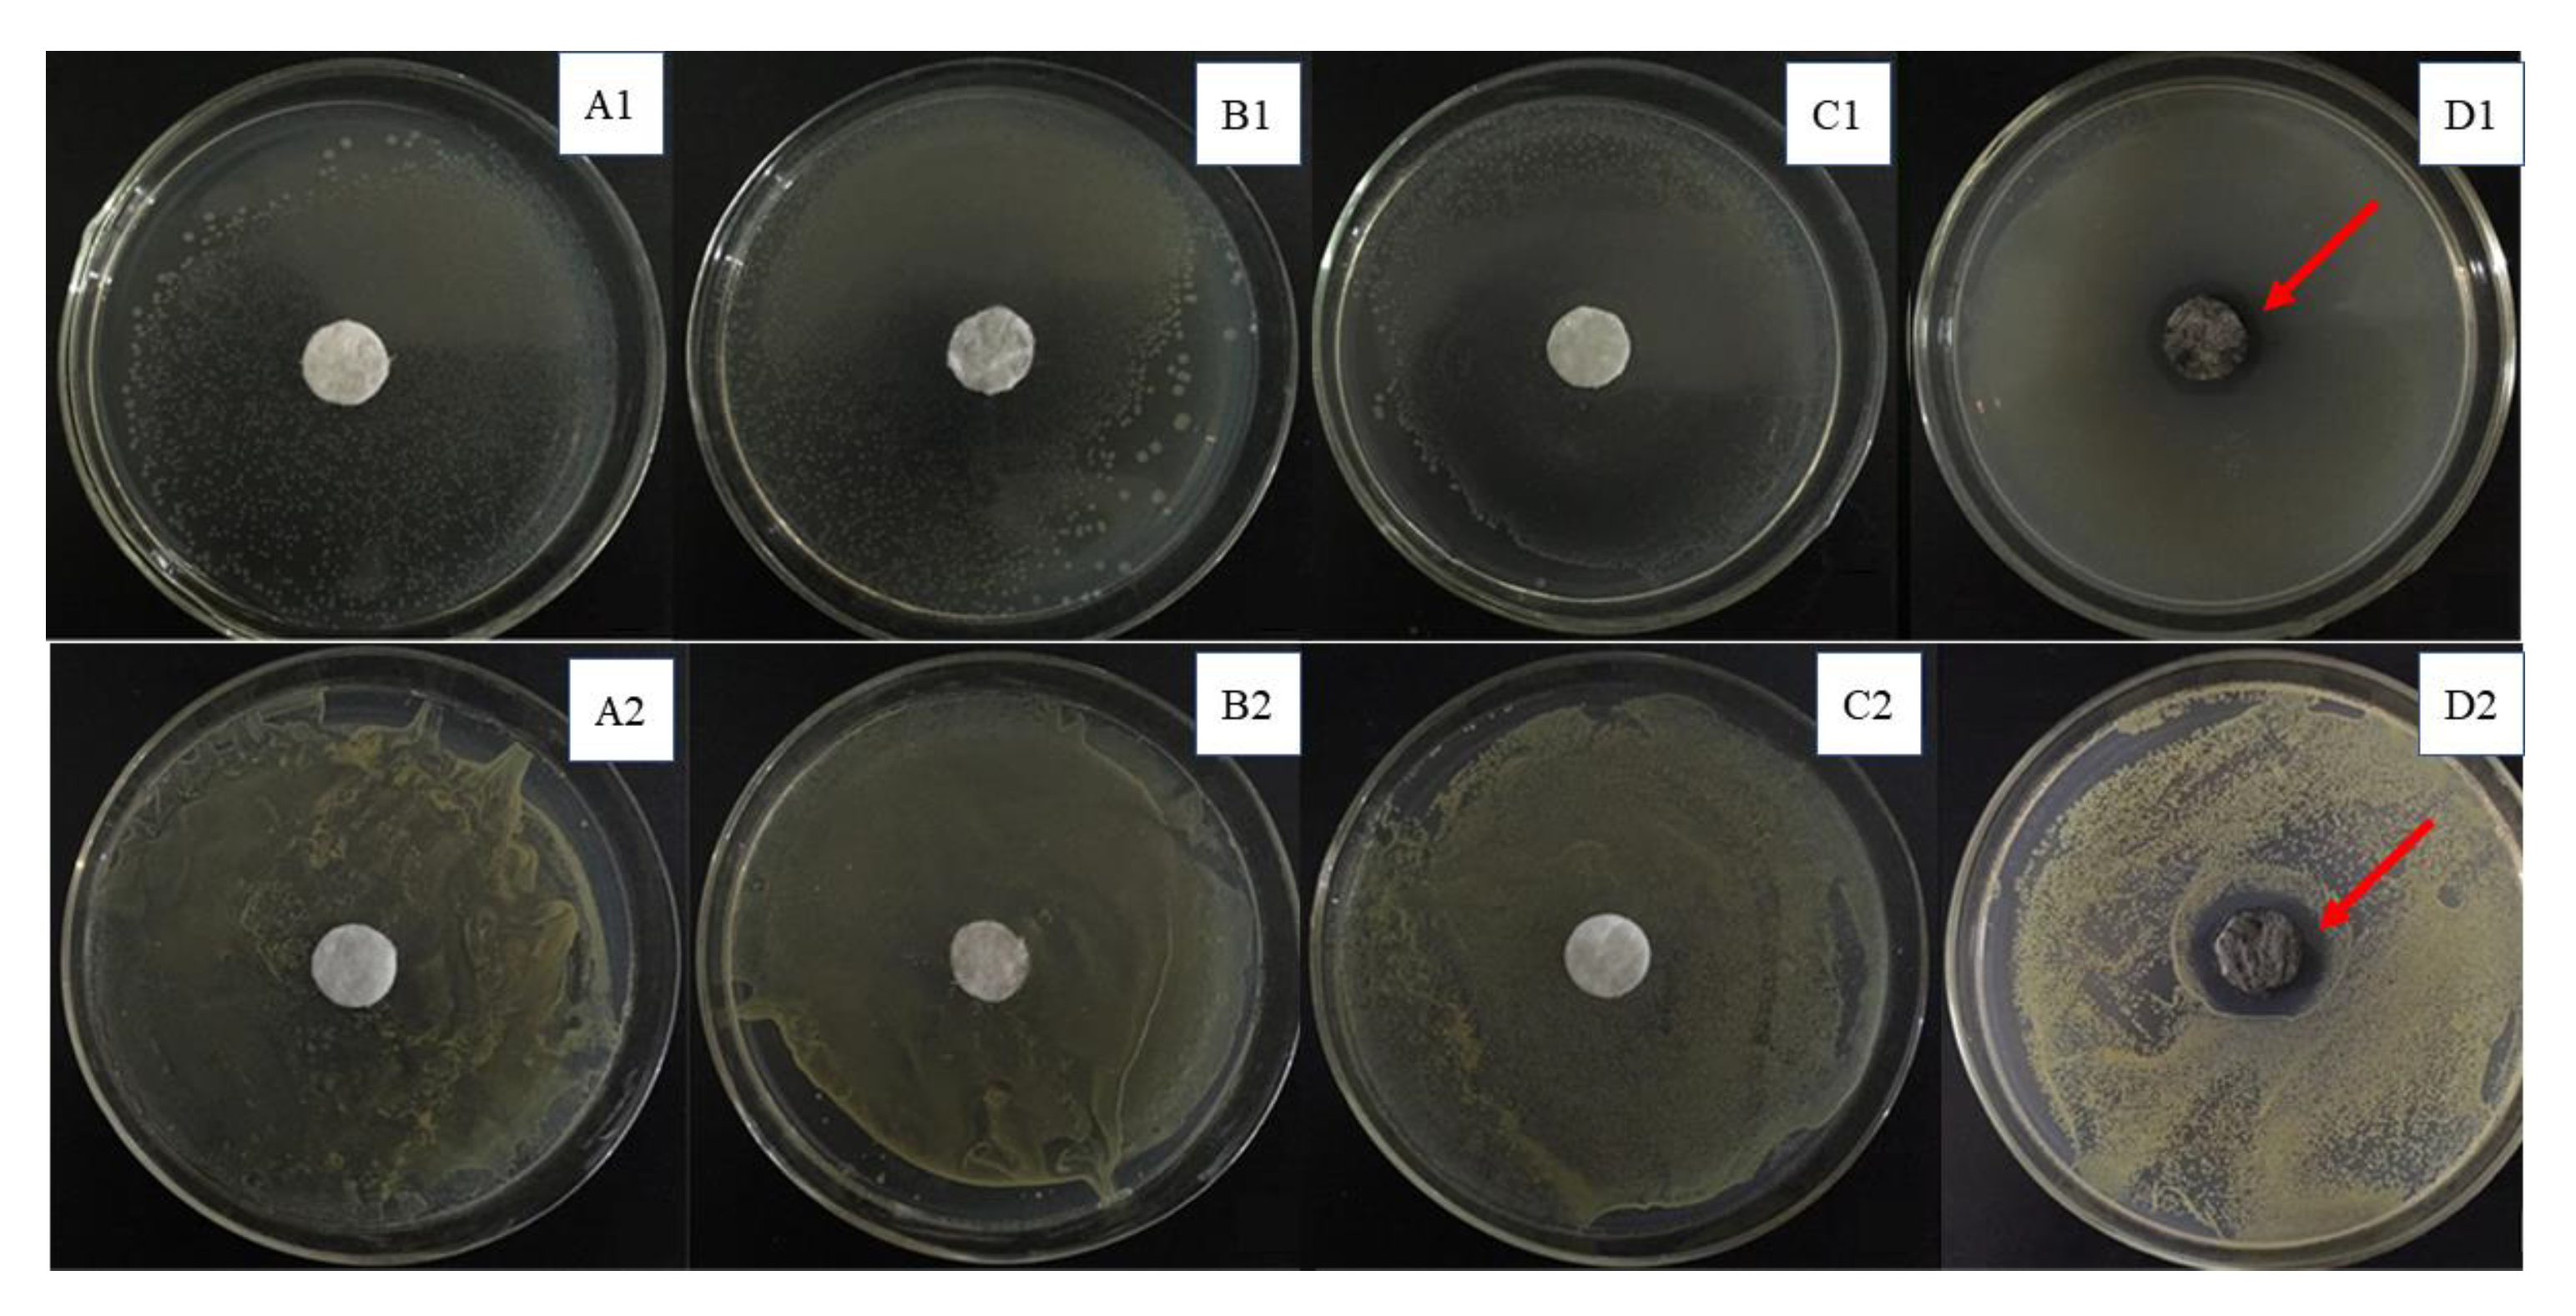

Enhanced Conductivity and Antibacterial Behavior of Cotton via the Electroless Deposition of Silver
Abstract
:1. Introduction
2. Experimental
2.1. Materials
2.2. Material Preparation
2.2.1. Preparation of the Cotton-Br
2.2.2. Preparation of Cotton-METAC
2.2.3. Preparation of Cotton-METAC-Pd
2.2.4. Preparation of Copper Electroless Deposition Solution
2.2.5. Preparation of Silver Electroless Deposition Solution
2.2.6. Preparation of the Cotton-Ag
2.3. Material Characterization
2.4. Antibacterial Behavior
3. Results and Discussion
4. Conclusions
Author Contributions
Funding
Institutional Review Board Statement
Informed Consent Statement
Data Availability Statement
Conflicts of Interest
Sample Availability
References
- Yao, C.H.; Yin, X.; Yu, Y.H.; Cai, Z.Y.; Wang, X.D. Chemically Functionalized Natural Cellulose Materials for Effective Triboelectric Nano-generator Development. Adv. Funct. Mater. 2017, 27, 7. [Google Scholar] [CrossRef]
- Jur, J.S.; Sweet, W.J.; Oldham, C.J.; Parsons, G.N. Atomic Layer Deposition of Conductive Coatings on Cotton, Paper, and Synthetic Fi-bers: Conductivity Analysis and Functional Chemical Sensing Using “All-Fiber” Capacitors. Adv. Funct. Mater. 2011, 21, 1993–2002. [Google Scholar] [CrossRef]
- Cao, E.J.; Duan, W.Z.; Wang, F.; Wang, A.Q.; Zheng, Y. Natural cellulose fiber derived hollow-tubular-oriented polydopamine: In-situ for-mation of Ag nanoparticles for reduction of 4-nitrophenol. Carbohydr. Polym. 2017, 158, 44–50. [Google Scholar] [CrossRef]
- Ghosh, S.; Remanan, S.; Mondal, S.; Ganguly, S.; Das, P.; Singha, N.; Das, N.C. An approach to prepare mechanically robust full IPN strengthened conductive cotton fabric for high strain tolerant electromagnetic interference shielding. Chem. Eng. J. 2018, 344, 138–154. [Google Scholar] [CrossRef]
- Erdumlu, N.; Saricam, C. Electromagnetic shielding effectiveness of woven fabrics containing cotton/metal-wrapped hybrid yarns. J. Ind. Text. 2016, 46, 1084–1103. [Google Scholar] [CrossRef]
- Cheng, D.; He, M.; Ran, J.; Cai, G.; Wu, J.; Wang, X. In situ reduction of TiO2 nanoparticles on cotton fabrics through polydopamine templates for photocatalysis and UV protection. Cellulose 2018, 25, 1413–1424. [Google Scholar] [CrossRef]
- Zhang, S.; Yang, X.; Tang, B.; Yuan, L.; Wang, K.; Liu, X.; Zhu, X.; Li, J.; Ge, Z.; Chen, S. New insights into synergistic antimicrobial and antifouling cotton fabrics via dually finished with quaternary ammonium salt and zwitterionic sulfobetaine. Chem. Eng. J. 2018, 336, 123–132. [Google Scholar] [CrossRef]
- Zhu, T.; Li, S.; Huang, J.; Mihailiasa, M.; Lai, Y. Rational design of multi-layered superhydrophobic coating on cotton fabrics for UV shielding, self-cleaning and oil-water separation. Mater. Des. 2017, 134, 342–351. [Google Scholar] [CrossRef]
- Wu, M.; Ma, B.; Pan, T.; Chen, S.; Sun, J. Silver-Nanoparticle-Colored Cotton Fabrics with Tunable Colors and Durable Antibacterial and Self-Healing Superhydrophobic Properties. Adv. Funct. Mater. 2016, 26, 569–576. [Google Scholar] [CrossRef]
- Wang, C.X.; Lv, J.C.; Ren, Y.; Zhou, Q.Q.; Chen, J.Y.; Zhi, T.; Lu, Z.Q.; Gao, D.W.; Ma, Z.P.; Jin, L.M. Cotton fabric with plasma pretreatment and ZnO/Carboxymethyl chitosan composite finishing for durable UV resistance and antibacterial property. Carbohydr. Polym. 2016, 138, 106–113. [Google Scholar] [CrossRef]
- Kale, B.M.; Wiener, J.; Militky, J.; Rwawiire, S.; Mishra, R.; Jacob, K.I.; Wang, Y.J. Coating of cellulose-TiO2 nanoparticles on cotton fabric for durable photocatalytic self-cleaning and stiffness. Carbohydr. Polym. 2016, 150, 107–113. [Google Scholar] [CrossRef] [PubMed]
- Li, L.; Zhong, Q.F.; Kim, N.D.; Ruan, G.D.; Yang, Y.; Gao, C.T.; Fei, H.L.; Li, Y.L.; Ji, Y.S.; Tour, J.M. Nitrogen-doped carbonized cotton for highly flex-ible supercapacitors. Carbon 2016, 105, 260–267. [Google Scholar] [CrossRef]
- Chung, S.-H.; Chang, C.-H.; Manthiram, A. A Carbon-Cotton Cathode with Ultrahigh-Loading Capability for Statically and Dynamically Stable Lithium–Sulfur Batteries. ACS Nano 2016, 10, 10462–10470. [Google Scholar] [CrossRef] [PubMed]
- Wei, Y.; Chen, S.; Lin, Y.; Yuan, X.; Liu, L. Silver nanowires coated on cotton for flexible pressure sensors. J. Mater. Chem. C 2016, 4, 935–943. [Google Scholar] [CrossRef]
- Lee, J.; Yoon, J.; Kim, H.G.; Kang, S.; Oh, W.-S.; Algadi, H.; Al-Sayari, S.; Shong, B.; Kim, S.-H.; Kim, H.; et al. Highly conductive and flexible fiber for textile electronics obtained by extremely low-temperature atomic layer deposition of Pt. NPG Asia Mater. 2016, 8, e331. [Google Scholar] [CrossRef] [Green Version]
- Hebeish, A.; Farag, S.; Sharaf, S.; Shaheen, T.I. Advancement in conductive cotton fabrics through in situ polymerization of polypyr-role-nanocellulose composites. Carbohydr. Polym. 2016, 151, 96–102. [Google Scholar] [CrossRef] [PubMed]
- Nooralian, Z.; Gashti, M.P.; Ebrahimi, I. Fabrication of a multifunctional graphene/polyvinylphosphonic acid/cotton nanocomposite via facile spray layer-by-layer assembly. RSC Adv. 2016, 6, 23288–23299. [Google Scholar] [CrossRef] [Green Version]
- Liu, S.; Hu, M.; Yang, J. A facile way of fabricating a flexible and conductive cotton fabric. J. Mater. Chem. C 2016, 4, 1320–1325. [Google Scholar] [CrossRef]
- Atwa, Y.; Maheshwari, N.; Goldthorpe, I.A. Silver nanowire coated threads for electrically conductive textiles. J. Mater. Chem. C 2015, 3, 3908–3912. [Google Scholar] [CrossRef] [Green Version]
- Liao, Y.-C.; Kao, Z.-K. Direct Writing Patterns for Electroless Plated Copper Thin Film on Plastic Substrates. ACS Appl. Mater. Interfaces 2012, 4, 5109–5113. [Google Scholar] [CrossRef]
- Zhang, F.-T.; Xu, L.; Chen, J.-H.; Zhao, B.; Fu, X.-Z.; Sun, R.; Chen, Q.; Wong, C.-P. Electroless Deposition Metals on Poly(dimethylsiloxane) with Strong Adhesion as Flexible and Stretchable Conductive Materials. ACS Appl. Mater. Interfaces 2018, 10, 2075–2082. [Google Scholar] [CrossRef] [PubMed]
- Suryaprabha, T.; Sethuraman, M. Design of electrically conductive superhydrophobic antibacterial cotton fabric through hierarchical architecture using bimetallic deposition. J. Alloys Compd. 2017, 724, 240–248. [Google Scholar] [CrossRef]
- Ma, Z.; Xu, R.; Wang, W.; Yu, D. A wearable, anti-bacterial strain sensor prepared by silver plated cotton/spandex blended fabric for human motion monitoring. Colloids Surf. A Physicochem. Eng. Asp. 2019, 582, 123918. [Google Scholar] [CrossRef]
- Liu, H.; Zhu, L.; Xue, J.; Hao, L.; Li, J.; He, Y.; Cheng, B. A Novel Two-Step Method for Fabricating Silver Plating Cotton Fabrics. J. Nanomater. 2016, 2016, 1–11. [Google Scholar] [CrossRef] [Green Version]
- Wang, L.; He, D.D.; Li, J.R.; He, B.H.; Qian, L.Y. Conductive cotton fabrics with ultrahigh washability by electroless silver plating after silane modification. Cellulose 2021, 28, 5881–5893. [Google Scholar] [CrossRef]
- Tan, Y.-J.; Li, J.; Gao, Y.; Li, J.; Guo, S.; Wang, M. A facile approach to fabricating silver-coated cotton fiber non-woven fabrics for ultrahigh electromagnetic interference shielding. Appl. Surf. Sci. 2018, 458, 236–244. [Google Scholar] [CrossRef]
- Liu, X.Q.; Chang, H.X.; Li, Y.; Huck, W.T.S.; Zheng, Z.J. Polyelectrolyte-Bridged Metal/Cotton Hierarchical Structures for Highly Durable Conductive Yarns. ACS Appl. Mater. Interfaces 2010, 2, 529–535. [Google Scholar] [CrossRef] [PubMed]
- Guo, R.S.; Yu, Y.; Xie, Z.; Liu, X.Q.; Zhou, X.C.; Gao, Y.F.; Liu, Z.L.; Zhou, F.; Yang, Y.; Zheng, Z.J. Matrix-assisted catalytic printing for the fabrication of multiscale, flexible, foldable, and stretchable metal conductors. Adv. Mater. 2013, 25, 3343–3350. [Google Scholar] [CrossRef]
- Irfan, M.; Perero, S.; Miola, M.; Maina, G.; Ferri, A.; Ferraris, M.; Balagna, C. Antimicrobial functionalization of cotton fabric with silver nanoclusters/silica composite coating via RF co-sputtering technique. Cellulose 2017, 24, 2331–2345. [Google Scholar] [CrossRef]
- Mohamed, I.M.A.; Dao, V.D.; Yasin, A.S.; Mousa, H.M.; Yassin, M.A.; Khan, M.Y.; Choi, H.S.; Barakat, N.A.M. Physicochemical and pho-to-electrochemical characterization of novel N-doped nanocomposite ZrO2/TiO2 photoanode towards technology of dye-sensitized solar cells. Mater. Charact. 2017, 127, 357–364. [Google Scholar] [CrossRef]
- Su, J.; Wang, W.F.; Lei, Y.; Zhang, L.; Xu, L.H.; Wang, D.; Lu, D.; Bai, Y. On the growth of CH3NH3PbI3-xClx single crystal and characterization. Phys. B Condens. Matter 2018, 537, 7–11. [Google Scholar] [CrossRef]
- Fanfoni, L.; Marsich, E.; Turco, G.; Breschi, L.; Cadenaro, M. Development of di-methacrylate quaternary ammonium monomers with antibacterial activity. Acta Biomater. 2021, 129, 138–147. [Google Scholar] [CrossRef] [PubMed]
- Shah, H.N.; Gharbia, S.E.; Collins, M.D. The Gram stain: A declining synapomorphy in an emerging evolutionary tree. Rev. Med. Microbiol. 1997, 8, 103–110. [Google Scholar] [CrossRef]

Publisher’s Note: MDPI stays neutral with regard to jurisdictional claims in published maps and institutional affiliations. |
© 2021 by the authors. Licensee MDPI, Basel, Switzerland. This article is an open access article distributed under the terms and conditions of the Creative Commons Attribution (CC BY) license (https://creativecommons.org/licenses/by/4.0/).
Share and Cite
Liu, C.; Liao, D.; Ma, F.; Huang, Z.; Liu, J.; Mohamed, I.M.A. Enhanced Conductivity and Antibacterial Behavior of Cotton via the Electroless Deposition of Silver. Molecules 2021, 26, 4731. https://doi.org/10.3390/molecules26164731
Liu C, Liao D, Ma F, Huang Z, Liu J, Mohamed IMA. Enhanced Conductivity and Antibacterial Behavior of Cotton via the Electroless Deposition of Silver. Molecules. 2021; 26(16):4731. https://doi.org/10.3390/molecules26164731
Chicago/Turabian StyleLiu, Changkun, Dan Liao, Fuqing Ma, Zenan Huang, Ji’an Liu, and Ibrahim M. A. Mohamed. 2021. "Enhanced Conductivity and Antibacterial Behavior of Cotton via the Electroless Deposition of Silver" Molecules 26, no. 16: 4731. https://doi.org/10.3390/molecules26164731
APA StyleLiu, C., Liao, D., Ma, F., Huang, Z., Liu, J., & Mohamed, I. M. A. (2021). Enhanced Conductivity and Antibacterial Behavior of Cotton via the Electroless Deposition of Silver. Molecules, 26(16), 4731. https://doi.org/10.3390/molecules26164731

